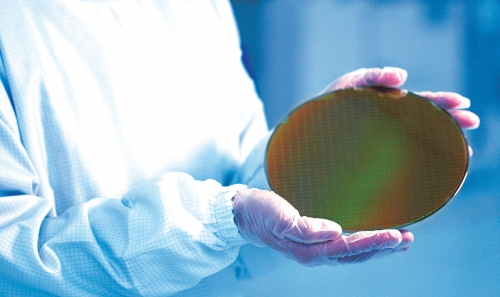
半导体无尘洁净——我们一直在努力

聚势开门红丨开工启新程 奋楫向未来
荣耀开工再启新程春启新章,奋楫争先。正月初八,迈思德正式开工,全体员工齐聚一堂,以满格斗志迎战202...

荣耀开工再启新程春启新章,奋楫争先。正月初八,迈思德正式开工,全体员工齐聚一堂,以满格斗志迎战202...

2026迈思德集团年会MYESDE岁序常易,华章日新。2月9日,2026迈思德集团年会颁奖典礼暨迎春...

在 2024 年的征程中,迈思德一路砥砺前行,书写了属于自己的精彩篇章,在创新、品质、服务等方...

10月24日,长三角洁净技术高峰论坛于上海淳大万丽酒店盛大启幕,宛如一颗璀璨的明珠,吸引了众多...

2024年7月27日,最准免费资料大全在“阻断微污染,助力高科技"的使命驱动...

“双碳”目标的提出,推动了新能源汽车产业步入发展的快车道。在政府有效的政策引导下,新能源汽车技术创新...
由于生产环境不清洁导致零部件可靠性差、质量不稳定,从而直接决定了最终产品的成败,无尘洁净在半导体行业...

来访的客户是半导体龙头企业,主要生产高纯多晶硅材料,对无尘布有着很高的要求,目前无尘布方面除我们迈思...

大家好,我是Sally,现任职迈思德超净科技有限公司的大客户经理,在职5年主要服务新能源客户,对于无...

近年来电子集成器件向小型化、高性能的趋势发展,印刷电路板上可供贴装的单位面积趋近物理极限,已经无法满...

2021年3月,最准免费资料大全参加了为期三天中国(上海)国际半导体展会。迈思德展示了公司...

迈思德南通新工厂于2020年12月2日上午10:08,一城瞩目,荣耀启程,在社会各界关怀下,迎来了隆...